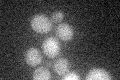
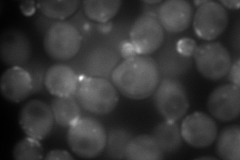
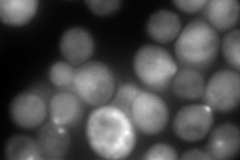
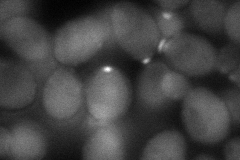
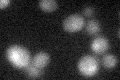

View description
Calmodulin; Ca++ binding protein that regulates Ca++ independent processes (mitosis, bud growth, actin organization, endocytosis, etc.) and Ca++ dependent processes (stress-activated pathways), targets include Nuf1p, Myo2p and calcineurin
Localization:
Intensity:
Fold change:
Significance:
-
C’ GFP library in SD
below threshold14.92 -
N' NOP1pr-GFP in SD
bud,bud neck303.362 -
N' TEF2pr-mCherry in SD
bud,bud neck606.359 -
N' NATIVEpr-GFP in SD

punctate,bud154.227 -
N' TEF2pr-VC and Cyto-VN in SD
cytosol,bud78.2254 -
C’ GFP library in SD+DTT
cytosolN/AN/ANo -
C’ GFP library in SD+H2O2

cytosolN/AN/ANo -
C’ GFP library in Starvation Media

cytosolN/AN/AYes -
C’ GFP library on the background of Pup2-DaMP

below threshold -
C’ GFP library on the background of CCT mutant

below thresholdN/AN/ANo
